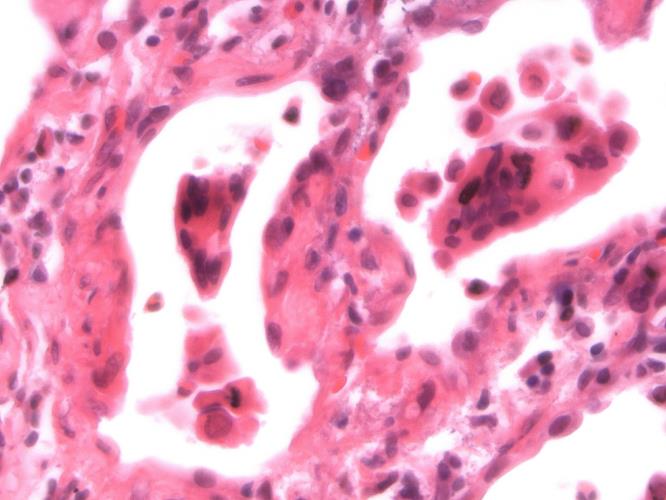
Αναγκαία όσο ποτέ η ευαισθητοποίηση για πρόληψη και έγκαιρη διάγνωση

Το μήνυμα της ανάγκης ύπαρξης σωστής ενημέρωσης για την πρόληψη του κοινού από την πνευμονία, στέλνει σε γραπτό του μήνυμα ο Επίτροπος Εθελοντισμού, Γιαννάκης Γιαννάκη με αφορμή την Παγκόσμια Ημέρα κατά της πνευμονίας στις 12 Νοεμβρίου.
Όπως επισημαίνει ο κ. Γιαννάκη, η επικέντρωση των προσπαθειών σε δράσεις ενημέρωσης του κοινού είναι σημαντική ως μέτρο πρόληψης και έγκαιρης διάγνωσης της νόσου. Οι αριθμοί θανάτων παιδιών και ενηλίκων κάθε χρόνο από την πνευμονία καταδεικνύουν την ανάγκη πρόληψης και έγκαιρης διάγνωσης της ασθένειας.
"Η Παγκόσμια Ημέρα Πνευμονίας επιδιώκει να αυξήσει την ευαισθητοποίηση του κοινού σχετικά με το ότι η πνευμονία είναι θέμα δημόσιας υγείας. Σκοπός της είναι να βοηθήσει στην πρόληψη των εκατομμυρίων θανάτων μικρών παιδιών από πνευμονία που συμβαίνουν κάθε χρόνο. Γενικά η καθιέρωση της ημέρας αυτής στοχεύει στο να υπενθυμίσει την κοινή γνώμη ότι η πνευμονία αποτελεί μια από τις κυριότερες αιτίες θανάτου για τα παιδιά κάτω των πέντε ετών, και να προωθήσει πρωτοβουλίες και δράσεις για την πρόληψη και τη θεραπεία της ασθένειας".
Η παιδική πνευμονία, σημειώνει, αποτελούσε μέχρι το 2013, την πρώτη κυριότερη αιτία θανάτου των παιδιών κάτω των πέντε ετών παγκοσμίως. "Το 2013, για πρώτη φορά κατατάσσεται δεύτερη μετά από τις επιπλοκές στον τοκετό, σύμφωνα με στοιχεία που δημοσιεύθηκαν πρόσφατα από τη UNICEF ως αποτέλεσμα της μείωσης των θανάτων από τη νόσο κατά 44% από το 2000". Παρόλα αυτά ένα παιδί πεθαίνει από πνευμονία κάθε 25 δευτερόλεπτα με τον αριθμό τους να ανέρχεται στα 954.000 παιδιά ετησίως, παρατηρεί. "Όπως και σε περιπτώσεις ασθενειών, τα θύματα βρίσκονται στις φτωχότερες χώρες του κόσμου που δεν έχουν τη δυνατότητα να παρέχουν εμβόλια και την κατάλληλη ιατρική περίθαλψη. Σύμφωνα με την UNICEF, το 90% των παιδικών θανάτων από πνευμονία επικεντρώνεται στην Υπό τη Σαχάρα Αφρική και τη Νότια Ασία".
Ο κ. Γιαννάκη αναφέρει ότι η Παγκόσμια Ημέρα κατά της Πνευμονίας καθιερώθηκε το 2009, με πρωτοβουλία του Παγκόσμιου Συνασπισμού κατά της Παιδικής Πνευμονίας μετά από τη σύμπραξη 125 μη κυβερνητικών οργανώσεων, κινημάτων πολιτών και κυβερνητικών οργανώσεων, προκειμένου να υποστηριχθούν οι προσπάθειες όλων των εμπλεκομένων φορέων για την αντιμετώπιση της νόσου.
Η έγκαιρη διάγνωση και θεραπεία της πνευμονίας, η χρήση των εμβολίων κατά της πνευμονίας, καθώς και η πρόσβαση σε υγειονομική περίθαλψη, σώζουν ζωές, αναφέρει ο Επίτροπος Εθελοντισμού λέγοντας πως απλά μέτρα, όπως ο έγκαιρος και αποκλειστικός μητρικός θηλασμός, το πλύσιμο των χεριών με σαπούνι, καθαρό οικιακό περιβάλλον, συμπεριλαμβανομένου του ασφαλούς πόσιμου νερού και βελτιωμένων εγκαταστάσεων υγιεινής, και η παροχή θρεπτικών ιχνοστοιχείων συμβάλλουν ώστε να μειωθούν τα περιστατικά πνευμονίας.
Όπως επισημαίνει ο κ. Γιαννάκη, η επικέντρωση των προσπαθειών σε δράσεις ενημέρωσης του κοινού είναι σημαντική ως μέτρο πρόληψης και έγκαιρης διάγνωσης της νόσου. Οι αριθμοί θανάτων παιδιών και ενηλίκων κάθε χρόνο από την πνευμονία καταδεικνύουν την ανάγκη πρόληψης και έγκαιρης διάγνωσης της ασθένειας.
"Η Παγκόσμια Ημέρα Πνευμονίας επιδιώκει να αυξήσει την ευαισθητοποίηση του κοινού σχετικά με το ότι η πνευμονία είναι θέμα δημόσιας υγείας. Σκοπός της είναι να βοηθήσει στην πρόληψη των εκατομμυρίων θανάτων μικρών παιδιών από πνευμονία που συμβαίνουν κάθε χρόνο. Γενικά η καθιέρωση της ημέρας αυτής στοχεύει στο να υπενθυμίσει την κοινή γνώμη ότι η πνευμονία αποτελεί μια από τις κυριότερες αιτίες θανάτου για τα παιδιά κάτω των πέντε ετών, και να προωθήσει πρωτοβουλίες και δράσεις για την πρόληψη και τη θεραπεία της ασθένειας".
Η παιδική πνευμονία, σημειώνει, αποτελούσε μέχρι το 2013, την πρώτη κυριότερη αιτία θανάτου των παιδιών κάτω των πέντε ετών παγκοσμίως. "Το 2013, για πρώτη φορά κατατάσσεται δεύτερη μετά από τις επιπλοκές στον τοκετό, σύμφωνα με στοιχεία που δημοσιεύθηκαν πρόσφατα από τη UNICEF ως αποτέλεσμα της μείωσης των θανάτων από τη νόσο κατά 44% από το 2000". Παρόλα αυτά ένα παιδί πεθαίνει από πνευμονία κάθε 25 δευτερόλεπτα με τον αριθμό τους να ανέρχεται στα 954.000 παιδιά ετησίως, παρατηρεί. "Όπως και σε περιπτώσεις ασθενειών, τα θύματα βρίσκονται στις φτωχότερες χώρες του κόσμου που δεν έχουν τη δυνατότητα να παρέχουν εμβόλια και την κατάλληλη ιατρική περίθαλψη. Σύμφωνα με την UNICEF, το 90% των παιδικών θανάτων από πνευμονία επικεντρώνεται στην Υπό τη Σαχάρα Αφρική και τη Νότια Ασία".
Ο κ. Γιαννάκη αναφέρει ότι η Παγκόσμια Ημέρα κατά της Πνευμονίας καθιερώθηκε το 2009, με πρωτοβουλία του Παγκόσμιου Συνασπισμού κατά της Παιδικής Πνευμονίας μετά από τη σύμπραξη 125 μη κυβερνητικών οργανώσεων, κινημάτων πολιτών και κυβερνητικών οργανώσεων, προκειμένου να υποστηριχθούν οι προσπάθειες όλων των εμπλεκομένων φορέων για την αντιμετώπιση της νόσου.
Η έγκαιρη διάγνωση και θεραπεία της πνευμονίας, η χρήση των εμβολίων κατά της πνευμονίας, καθώς και η πρόσβαση σε υγειονομική περίθαλψη, σώζουν ζωές, αναφέρει ο Επίτροπος Εθελοντισμού λέγοντας πως απλά μέτρα, όπως ο έγκαιρος και αποκλειστικός μητρικός θηλασμός, το πλύσιμο των χεριών με σαπούνι, καθαρό οικιακό περιβάλλον, συμπεριλαμβανομένου του ασφαλούς πόσιμου νερού και βελτιωμένων εγκαταστάσεων υγιεινής, και η παροχή θρεπτικών ιχνοστοιχείων συμβάλλουν ώστε να μειωθούν τα περιστατικά πνευμονίας.